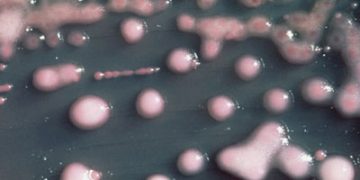
O bacterie rezistentă la aproape toate antibioticele riscă să se răspândească în întreaga lume

O bacterie rezistentă la aproape toate antibioticele a fost descoperită în spitalele britanice, fiind adusă de persoane care au călătorit în Asia de Sud pentru îngrijiri medicale, relevă un studiu care sugerează că există un risc de răspândire la nivel mondial.
Bacteria, care produce enzima de tip “New Delhi metalo-beta-lactamază” (NDM-1), a fost identificată prima dată în 2009, de profesorul Timothy Walsh, la un pacient suedez care fusese tratat în India.
Potrivit unui studiu publicat în revista britanică The Lancet Infectious Diseases, cercetătorii au izolat 37 de pacienţi în Marea Britanie, mulţi dintre care călătoriseră în India şi Pakistan pentru operaţii estetice. “NDM-1 are potenţialul de a se transmite la nivel mondial; este necesară o supraveghere coordonată”, avertizează autorii studiului, explicând că numeroşi pacienţi europeni şi americani apelează la servicii de chirurgie estetică în India.
NDM-1 rezistă practic la toate tipurile de antibiotice, inclusiv la carbapenem, folosit de obicei în cazuri de infecţii grave.
“Cu acest gen de bacterie, practic am epuizat antibioticele. Doar două tipuri de antibiotice o pot combate, iar unul nu a fost foarte eficient. Nu vor mai exista antibiotice disponibile în următorii zece ani. Dacă se va permite perpetuarea acestor infecţii fără tratamente adecvate, vom asista la o anumită mortalitate”, avertizează Walsh.
“Ne trebuie un mecanism de supraveghere la scară globală şi noi antibiotice pentru astfel de bacterii”, subliniază specialistul.
Cel puţin 44 de cazuri de NDM-1 au fost depistate în statul indian Tamil Nadu, 26 în statul Haryana, precum şi în Bangladesh şi Pakistan.
Profesorul Johann Pitout a declarat că astfel de cazuri au fost depistate şi în Statele Unite, Olanda, Australia şi Canada, la persoane care beneficiaseră de servicii medicale în India.